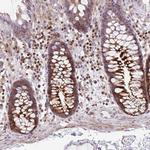
GRF-1 Antibody in Immunohistochemistry (Paraffin) (IHC (P))

Search
Invitrogen
GRF-1 Polyclonal Antibody
{{$productOrderCtrl.translations['antibody.pdp.commerceCard.promotion.promotions']}}
{{$productOrderCtrl.translations['antibody.pdp.commerceCard.promotion.viewpromo']}}
{{$productOrderCtrl.translations['antibody.pdp.commerceCard.promotion.promocode']}}: {{promo.promoCode}} {{promo.promoTitle}} {{promo.promoDescription}}. {{$productOrderCtrl.translations['antibody.pdp.commerceCard.promotion.learnmore']}}
产品信息
PA5-84293
种属反应
宿主/亚型
分类
类型
抗原
偶联物
形式
浓度
规格
纯化类型
保存液
内含物
保存条件
运输条件
RRID
产品详细信息
Immunogen sequence: VNVDLAFSTL VQLIDKSRGK TKIIPYFEAL KQQSQQIATA KDKYEWLVSR IVKNHNENWL SVSRKMQASP EYQDYVYLEG TQKAKKLF
Highest antigen sequence indentity to the following orthologs: Rat - 99%, Mouse - 99%.
靶标信息
RNA polymerase (pol) III synthesizes tRNA, 5s rRNA, 7SL RNA and U6 snRNA and is overexpressed in many transformed cell lines and tumors in vivo, since cells must duplicate its protein components before division. Therefore, in order to maintain rapid growth, cells must produce a high level of Pol III transcribed RNA, which requires the presence of the TFIIIB and TFIIIC2 transcription factor complexes. The TFIIIC2 complex is composed of five subunits, TFIIIC220, TFIIIC110, TFIIIC102, TFIIIC90 and TFIIIC63, that are overexpressed in adenovirus transformed cells as well as in malignant cells in vivo, such as ovarian carcinomas. TFIIIC2 recruits RNA pol III and TFIIIB to promoter elements and may be a key component in the deregulation of malignant cells. The TFIIIB complex includes the TATA-binding protein (TBP), TFIIB-related factor 1 (TFIIIB90, BRF1) and TFIIIB, the expression of which are also upregulated in transformed cells. In many carcinomas, the tumor suppressors retinoblastoma (RB) and p53 are inactivated, which affects their ability to bind and inactivate the function of TFIIIB.
仅用于科研。不用于诊断过程。未经明确授权不得转售。
篇参考文献 (0)
生物信息学
蛋白别名: Glucocorticoid receptor DNA-binding factor 1; Glucocorticoid receptor repression factor 1; GRF-1; MGC10745; p190-A; Rho GAP p190A; Rho GTPase-activating protein 35; tumor suppressor; unnamed protein product
基因别名: ARHGAP35; GRF-1; GRF1; GRLF1; KIAA1722; P190-A; P190A; p190ARHOGAP; p190RhoGAP
UniProt ID: (Human) Q9NRY4
Entrez Gene ID: (Human) 2909